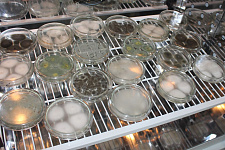

Учёные НИУ «БелГУ» назвали эффективные эфирные масла для создания противогрибковых биопрепаратов
В рамках НОЦ «Инновационные решения в АПК» биотехнологи оценили влияние натуральных масел лекарственных растений на фитопатогенные штаммы плесневых грибов

Для защиты растений от грибков сегодня используют химические фунгициды, которые представляют угрозу живым организмам и способны циркулировать в глобальном круговороте до ста лет. Однако ученые отмечают, что глобальные вызовы, прежде всего экологизация сельскохозяйственного производства, диктуют необходимость поиска безопасных средств защиты растений. Наибольшую опасность для сельскохозяйственных растений и урожая в целом представляют плесневые грибы альтенария и кладоспориум. Так, в Белгороде пять лет назад индекс развития альтернариоза достиг 45%, в результате чего растения начали отмирать или терять семенную продуктивность, а дефицит урожайности составил 12%.
В ходе исследования, проведенного на базе кафедры биотехнологии и микробиологии НИУ «БелГУ» под руководством доцента кафедры кандидата сельскохозяйственных наук Юлии Куркиной, была изучена эффективность использования эфирных масел лекарственных растений в качестве основы биофунгицидов – экологически чистых средств защиты растений.
В эфирных маслах содержится высокое количество дубильных веществ, флавоноидов, простых фенолов и их гликозидов, фенольных кислот, фенольных спиртов, антоцианов, что определяет их фитонцидные свойства, которые давно используются для подавления роста фитопатогенных микроорганизмов и формирования фитоиммунитета. В рамках лабораторного эксперимента на примере пораженных этими плесневыми грибами листьев овощных бобов биотехнологи изучили противогрибковую активность аптечных образцов натуральных эфирных масел – полыни, гвоздики, кориандра, лаванды, базилика, аниса, розмарина и чабреца.
– По предложенной нами 5-балльной шкале мы высоко оценили фунгицидное действие на оба штамма фитопатогенов только трех масел – базилика, кориандра и чабреца. В их присутствии колонии фитопатогенов вообще не росли. Остальные эфирные масла, хотя и обладали фунгистатическими свойствами (способностью останавливать рост гриба), в значительной степени проявляли видовую специфичность по отношению к плесеням, – комментирует результаты исследования Юлия Николаевна.
Для дальнейших исследований в области создания биопрепаратов для защиты растений от альтернариоза и кладоспориоза ученые рекомендуют использовать эфирные масла растений с комплексным в отношении обоих фитопатогенов действием. Прежде всего, это фунгицидные масла базилика, кориандра, чабреца, которые полностью подавляют рост грибов, а также натуральное эфирное масло лаванды с сильной фунгистатической активностью.
Результаты исследования представлены в научной статье: http://www.ijpronline.com/ViewArticleDetail.aspx?ID=16829
07.10.2020
| << Назад к списку | | Просмотров: 3019 |
Войти, чтобы оставить комментарий.